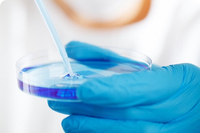

- Всички
- Име на продукта
- Ключова дума за продукт
- Продуктов модел
- Резюме на продукта
- Описание на продукта
- Търсене в множество полета

Болници


Изследователски институти

POCT

Биохимични лаборатории

GMP семинари

Училища
Контрол на заболяванията

Услуга за персонализиране